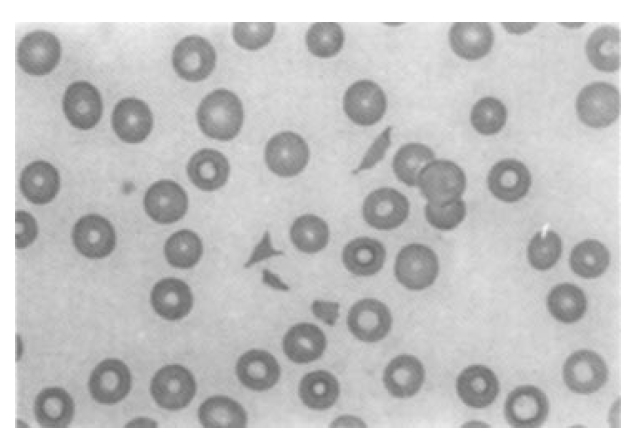

A Case of Wegener’s Granulomatosis Complicated by Diffuse Pulmonary Hemorrhage and Thrombotic Thrombocytopenic Purpura
Article information
Abstract
Wegener’s granulomatosis is a distinct form of necrotizing granulomatous vasculitis which usually affects the kidneys and the upper and lower respiratory tracts. Unusual manifestations have also been reported, and these include colitis, urethritis and diabetes insipidus. We describe a case of Wegener’s granulomatosis which presented with rapidly progressive renal insufficiency, sudden deafness, red eye, facial palsy, and complicated by uncommon manifestations that were diffuse pulmonary hemorrhage and thrombotic thrombocytopenic purpura.
INTRODUCTION
Wegener’s granulomatosis(WG) falls within the spectrum of systemic vasculitides as a clinicopathologic syndrome involving the upper and lower respiration tract and the kidney and, less commonly, the eyes, joints, skin, neurologic and cardiac tissue1). Diffuse pulmonary hemorrhage(DPH) is a relatively uncommon manifestation of WG but can be a first manifestation of WG2–4). We describe a case of WG diagnosed by pathologic finding and serologic marker(C-ANCA). While being treated, the patient was complicated by unusual manifestations of WG, including diffuse pulmonary hemorrhage and thrombotic thrombocytopenic purpura(TTP).
CASE REPORT
A 66-year-old woman presented on January 21, 1997 with abdominal pain, sudden deafness, facial palsy and oliguria. She had a 3-week history of nasal stuffness. Clinical examinations revealed no specific findings except red eye, nasal ulceration and high blood pressure(160/100mmHg). Plasma creatinine value was 6.2mg/dL and urinalysis showed many red blood cell and proteinuria (>300mg/dL). Erythrocyte sedimentation rate was 47mm/h; C-reactive protein 209ug/mL; leukocyte 13600/mm3 with 85% polymorphonuclear neutrophils; hemoglobin 9.9g/dL; platelet 221000/mm3. Rheumatoid factor, antinuclear antibodies, anti-ds DNA antibody and cryoglobulin were not detected. Complement concentrations(C3 and C4) were normal. Ultrasonography showed normal sized kidneys with no evidence of obstruction or cortical atrophy, and brain MRI showed no specific findings except for maxillary sinusitis. Serology showed ANCA positive (C-ANCA pattern) in a titer of 1:640 (Fig. 1) and nasal septal biopsy showed the necrotizing granulomatous vasculitis.(Fig. 2,3).

Positive C-ANCA in immunofluorescence testing(×100). Centrally accentuated finely granular cytoplasmic immunofluorescence is present in all neutrophils, with no stanining of neutrophil polymorphonuclear lobes.

Nasal septal biopsy shows granulomatous inflammtion with central neutrophilic infiltration and surrounding zone of histiocytes in cental area. The peripheral area shows dense lymphocytic infiltration(H & E stain, ×100)

Nasal septal biopsy shows the small vessels’ wall diffusely infiltrated with leukocytes, perivascular inflammation(H & E stain, ×400)
Therapy was initiated on January 22, with hemodialysis thrice weekly, and on January 25, with intravenous methylprednisolone 0.5g/day for 3 days, followed by prednisone 75mg/day(1mg/Kg) orally. Cyclophosphamide 150mg/day(2mg/Kg) was also given orally. She gradually improved but, on January 31, she complained of dyspnea. Chest X-ray showed homogeneous, ill-defined, patch consolidation on right lung field(Fig. 4). Hemoglobin was 5.0g/dL, platelet 157,000/mm3 and HRCT showed diffuse pulmonary hemorrhage(Fig. 5) and bronchoscopic examination showed fresh oozing blood from distal airway. Subsequently, diffuse pulmonary hemorrhage developed in left lung field. She was treated with transfusion to a hemoglobin of 10.8g/dL, ventilator care and second intravenous methlyprednisone 0.5g/day for 3 days. After that, prednisolone 75mg/day and cyclophosphamide 150mg/day were also given orally.

Chest radiogaph shows diffuse air-space consolidation with air-bronchogram in the whole right lung field.

HRCT of the chest shows nonsegmental ground glass opacity with air-bronchogram in the right lung field.
On February 5, the follow-up chest X-ray showed a much improved state but hemoglobin was decreased to 6.0g/dL; platelet 28,000/mm3. There was no clinical and laboratory evidence of hemorrhage, infection and disseminated intravascular coagulation. The peripheral blood smear showed many RBC fragments(Fig. 6); lactate dehydrogenase was increased to 902 IU/L(normal, <500IU/L) with LD1 flipped pattern; haptoglobin was reduced to below 5.8mg/L(normal, 16 to 20Omg/L); Coombs’ test and antiplatelet antibody were negative. Plasmapheresis was begun on February 10 and performed every day for 5 days.
Peripheral blood smear(Wright-Giemsa stain, ×1000) shows frequent irregular shaped erythrocyte fragments.
By February 19, hemoglobin was 9.2g/dL; platelet was 141,000/mm3 without further transfusion; follow-up titer of C-ANCA was 1:40; ESR and CRP were 6mm/h and negative respectively. Oliguria and all systemic symptoms had been resolved. She remains on maintenance oral cyclophosphamide and tapering doses of prednisolone.
DISCUSSION
Recently, for prompt diagnosis and institution of treatment, patients who have circulating ANCA vasculitis and upper and lower respiratory tract symptoms have been designated as Wegener’s syndrome, including classic WG and WG vasculitis5). The major sites of involvement are ear, nose, throat, lung and kidney6). Other major sites of involvement include the skin, with a variety of manifestations, including leukocytoclastic vasculitis and pyoderma gangrenosum; the nervous system, the chief sign being mononeuritis multiplex; the eye, displaying redness indicative of scleritis or episcleritis; the orbit, with pseudotumor causing proptosis; and the joints, manifesting a mono- or polyarticular migratory arthritis6). Diffuse alveolar hemorrhage was reported in 4 cases among 27 cases with ANCA associated vasculitis5) and 6 cases among 77 WG cases7). Diffuse alveolar hemorrhage is manifestated characteristically with hemoptysis, breathlessness, a diffuse alveolar filling pattern on chest roentgenogram and a profound anemia, and developed in fulminant WG6). In diffuse alveolar infiltrate on chest roentgenogram in WG, careful differential diagnosis between alveolar hemorrhage and infections is needed.
In our case, DPH was diagnosed by clinical and laboratory features, HRCT and bronchoscopic findings. Bronchoscopic findings in 51 WG patients showed hemorrhage without identifiable source in 2 cases, such as our case, probably due to hemorrhagic alveolar capillaritis8). By analysis of clinicopathologic characteristics and ANCA in 43 patients with DPH, underlying diseases were idiopathic pulmonary-renal syndrome(l6 cases), WG(10 cases), polyarteritis(11 cases), and isolated pulmonary hemorrhage(6 cases)9). No patients showed thrombotic microangiopathy simultaneously.
In WG, other unusual manifestations have also been reported, and these include colitis, urethritis, diabetes inspidus and microangiopathic hemolytic anemia10). Thrombotic microangiopathy has been described in many conditions, including hemolytic uremic syndrome, progressive systemic sclerosis, postpartum renal failure, malignant hypertension, membranous glomerulonephritis, systemic lupus erythematosus, polyarteritis nodosa, certain malignancies, infections, bone marrow transplant, and secondary to drugs such as cyclosporine A and estrogens5). Our patient did not have evidence of these conditions.
Heptinstall11) has described a case of hemolytic uremic syndrome associated with crescent glomerulonephritis, but ANCA status was not reported. Stave and Croker12) have described thrombotic microangiopathy in 6 of 12 patients with anti-glomerular basement membrane glomerulonephritis. Benitez et al13) have reported a case of platelet thrombi in polyarteritis nodosa, including glomerular capillary thrombi. A case of thrombotic microangiopathy in P-ANCA positive crescsentic glomerulonephritis was described. By Hirsch et al14). Crummy et al15) reported the unusual manifestations of microangiopathic hemolytic anemia and consumptive coagulopathy in WG for the first time. Jordan et al10) also reported a case of WG in which the disease was manifested with crescentic glomerulonephitis, upper airway ulcerations, microangiopathic hemolytic anemia with consumptive coagulopathy and breast mass, but DPH was not identified.
When microscopic vessels were predominantly involved (capillaritis), Boudes et al16) referred to this particular form of the disease as "microscopic Wegener’s disease" Microscopic Wegener’s disease is characterized by the association of microscopic vasculitis involving renal capillary or other vessels, such as lung capillary(with alveolar hemorrhage), the occurrence of microangiopathic hemolytic anemia and consumptive coagulopathy, the presence of C-ANCA as in our case, but does not show prominent granuloma on the other hand. In this case, thrombotic microangiopathy and crescentic gromerulonephritis had not been confirmed by biopsy, but the occurrence of microangiopathic hemolytic anemia and consumptive coagulopathy was diagnosed by clinical features and laboratory findings. DPH improved after second steroid pulse but on the other hand, microangiopathic hemolytic anemia, thrombocytopenia and fluctuation of consciousness appeared. To our knowlege, this association in WG has not been previously described in worldwide literature.
The therapeutic aspect of our case also deserves mention. It is now widely recognized that the mainstay of therapy in WG is cyclophosphamide. Plasma exchanges could have a favorable role, but their efficacy in WG remains uncertain. But plasmapheresis is a prerequisite to treatment of TTP, irrespective of the primary underlying disease. This case is characterized by the association of microscopic vasculitis involving renal capillary or other vessels, such as lung capillary, or with the occurrence of microangiopathic hemolytic anemia and consumptive coagulopathy. This particular feature of our report should be evaluated in the rare patient who has active WG.